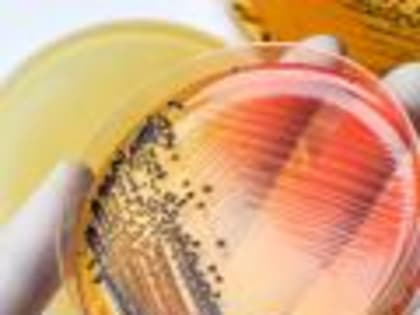
В полуфабрикатах птицы  специалистами Белгородской испытательной лаборатории обнаружены опасные патогены

Здоровье

Вице-спикер Госдумы РФ приехала в Белгородскую область и почтила память погибших 30 декабря
Фото: belregion.ru Затем она проведала юных пациентов в центре реабилитации детей, которые перенесли психические расстройства.

Белгородский Минздрав заявил о снижении детской смертности благодаря проекту «Здравоохранение»
Фото: ru.freepik.com Она уменьшилась на 40%. Минздрав Белгородской области подвёл итоги нацпроекта «Здравоохранение».

Лечение заболеваний и последствий травм спинного мозга.
В соответствии с постановлением Правительства области от 14 февраля 2022 года № 66-пп «Об утверждении Порядка обеспечения отдельных категорий инвалидов санаторно-курортными путевками в учреждения,

Фонд «Поколение» оказывает помощь белгородским детям с тяжелыми заболеваниями
Поддержку белгородским семьям с детьми, у которых тяжёлые заболевания, уже не первый год оказывает фонд «Поколение» депутата Госдумы Андрея Скоча, в том числе – приобретает необходимые препараты.

1 февраля на территории амбулатории с.Скородное проведена акция «День здоровья с.Скородное»
1 февраля на территории амбулатории с.Скородное проведена акция «День здоровья с.Скородное».

Сестринская конференция
В наступившем году цикл наших ежемесячных сестринских конференций открыли сотрудники отделения анестезиологии – реанимации.

В томатах специалисты Тамбовского отдела карантина растений Белгородской испытательной лаборатории обнаружили вирус мозаики пепино
В Белгородскую испытательную лабораторию ФГБУ «ВНИИЗЖ» Тамбовского отдела карантина растений в январе 2024 года поступили 22 образца плодов томатов для проведения исследования на карантинные заболевания.

В столице Белгородчины в куриных сердечках нашли листерию
Источник фото: Фото редакции В январе белгородская испытательная лаборатория для диагностики бактериальных болезней, пищевой микробиологии и приготовления питательных сред получила пробы субпродуктов птицы.
В полуфабрикатах птицы специалистами Белгородской испытательной лаборатории обнаружены опасные патогены
На прошлой неделе в отдел диагностики бактериальных болезней, пищевой микробиологии и приготовления питательных сред Белгородской испытательной лаборатории ФГБУ «ВНИИЗЖ» поступили пробы полуфабрикатов птицы.

Вячеслав Гладков рассказал о начале учений по ГО и ЧС в медучреждениях Белгорода
Фото: Павел Колядин / belpressa.ru Их проведут специалисты регионального министерства здравоохранения.